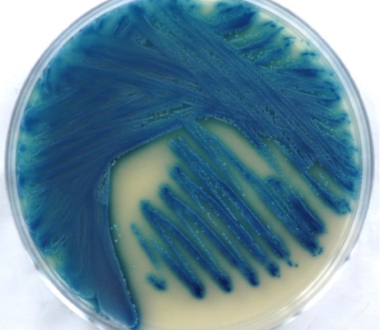
Candida blankii

The Wadsworth Center’s Mycology Laboratory has developed an in-house MALDI-TOF MS (matrix-assisted laser desorption ionization - time of flight mass spectrometry) library comprising rare yeast species, which is now one of the contributed databases available through the CDC’s MicrobeNet platform.
The epidemiology of invasive fungal infections (IFIs) has evolved in recent years, largely due to increased use of empirical antifungal therapies and the expanding population of immunocompromised patients. While Candida species remain the most common cause of IFIs globally, an increasing number of rare yeasts—both Candida and non-Candida species—have been implicated in sporadic outbreaks. Many of these organisms exhibit high levels of antifungal resistance, complicating clinical management and infection control efforts.
Accurate identification of these rare yeasts has been challenging due to limited reference databases for rapid testing. MALDI-TOF MS has transformed yeast identification at the species level, but its reliability depends on comprehensive library enrichment that captures the genetic diversity and epidemiological variation of circulating isolates.
To address this gap, the Wadsworth Center’s Mycology Laboratory has expanded its in-house Bruker MALDI library by adding 141 rare yeast isolates representing 25 genera and 68 species over the past two years. This enrichment has significantly reduced turnaround times for identifying rare yeasts and eliminated the need for Sanger sequencing of ribosomal genes—a time-consuming and labor-intensive process. The enhanced library also supports the rapid detection of yeasts with known antifungal resistance mechanisms.
This work, recently accepted for publication in Microbiology Spectrum, represents a significant contribution to the field. The resulting database of rare yeasts is now publicly accessible via the CDC’s MicrobeNet website (https://MicrobeNet.cdc.gov), where it will serve as a valuable national resource. Broader access to this library will facilitate accurate identification of an increasing number of rare yeasts, enabling appropriate antifungal therapy and helping to prevent the spread of these pathogens among vulnerable patient populations.